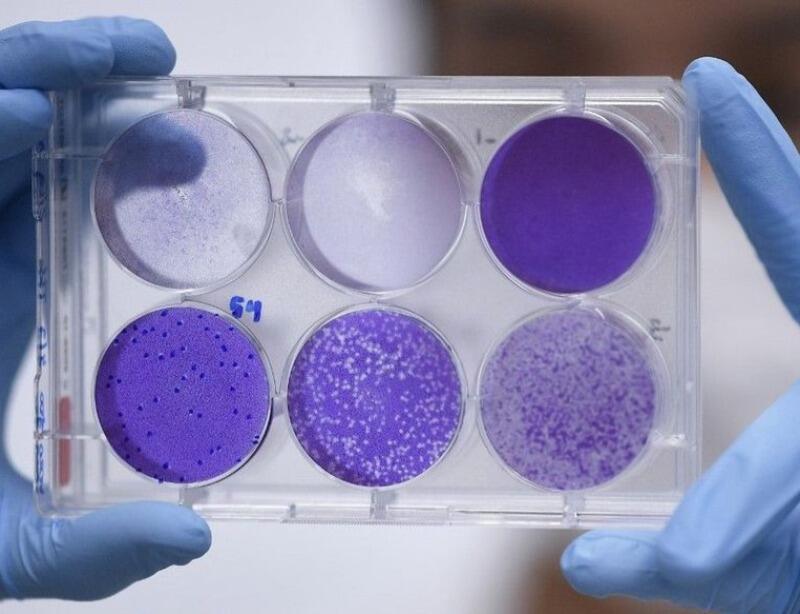

Uma vacina experimental contra o novo coronavírus apresentou pela primeira vez resultados promissores quando aplicada em um grupo de macacos, segundo o laboratório chinês Sinovac Biotech, que fez o experimento nesta sexta-feira (24). A informação é da agência de notícias France Presse.
Os resultados ainda precisam ser validados pela comunidade científica.
Para chegar a uma vacina efetiva, os pesquisadores precisam percorrer diversas etapas, passando por testes pré-clínicos, que podem ser in vitro ou em animais; e depois para os ensaios clínicos. Estima-se que uma vacina eficaz levará entre 12 e 18 meses para ser produzida.
Um balanço da Organização Mundial de Saúde (OMS), com dados até 20 de abril, aponta que até agora ao menos 76 pesquisas de vacinas estão em andamento em todo o mundo – 71 em fase pré-clínica e 5 em fase clínica.
Usando patógenos inertes do vírus que causa a Covid-19, a vacina foi ministrada em oito macacos Rhesus, que depois foram contaminados artificialmente, de acordo com os resultados do estudo, publicado pelo gigante farmacêutico Sinovac Biotech.
"Os quatro macacos que receberam a vacina em alta dose não tinham vestígios do vírus nos pulmões sete dias após a contaminação", afirmou o laboratório.
Outros quatro macacos, que receberam a mesma vacina, porém em doses mais baixas, apresentaram maior carga viral no corpo. Este grupo também conseguiu resistir à doença.
"Estes são os primeiros dados sérios que eu vejo sobre uma vacina experimental", disse Florian Krammer, virologista da Escola de Medicina Icahn em Nova York, no Twitter.
"A questão é se essa proteção dura muito tempo", questionou a imunologista Lucy Walker, da University College London.
Além do experimento do Sinovac, Pequim aprovou outros dois testes de vacina: um, em Hong Kong; e outro, em Wuhan, onde o patógeno emergiu no final do ano passado.
Testes de vacinas contra Covid-19 em humanos
Grupos farmacêuticos e laboratórios ao redor do mundo estão disputando uma corrida contra o tempo para desenvolver tratamento eficaz e uma vacina contra o Covid-19, que matou mais de 190 mil pessoas em todo mundo.
A Sinovac iniciou testes clínicos desta mesma vacina em seres humanos em 16 de abril. Consultada pela AFP, o laboratório não quis fazer comentários.
O laboratório americano Moderna também anunciou que está fazendo testes.
Nesta semana, o governo da Alemanha aprovou os primeiros testes clínicos de uma vacina contra o novo coronavírus. Duzentas pessoas saudáveis vão participar na primeira fase.
No Reino Unido, pesquisadores já testam outra vacina. Um dos cientistas da Universidade de Oxford disse que, se tudo der certo, as doses estariam disponíveis para o público no outono europeu, primavera no Hemisfério Sul. O laboratório já está produzindo a vacina em larga escala durante os testes, e assumiu o risco de jogar tudo fora se o produto for reprovado.
Etapas da vacina
Para chegar a uma vacina efetiva, os pesquisadores precisam percorrer diversas etapas. Entre elas está a pesquisa básica – que é o levantamento do tipo de vacina que pode ser feita. Depois, passam para os testes pré-clínicos, que podem ser in vitro ou em animais, para demonstrar a segurança do produto; e depois para os ensaios clínicos, que podem se desdobrar em outras quatro fases:
Fase 1: feita em seres humanos, para verificar a segurança da vacina nestes organismos
Fase 2: onde se estabelece qual a resposta imunológica do organismo (imunogenicidade)
Fase 3: última fase de estudo, para obter o registro sanitário
Fase 4: distribuição para a população